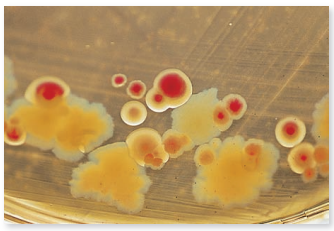
From chapter 3, figure 3.5 b. What biochemical characteristic does this figure illustrate How could this characteristic be used to begin the identification of these organisms Explain your answer. Figure 3.5 Examples of media that are both selective and differential. (b) MacConkey agar selects against gram-positive bacteria. It also differentiates between lactose-fermenting bacteria (indicated by a pink-red reaction in the center of the colony) and lactose-negative bacteria (indicated by an off-white colony with no dye reaction).

Microbiology: A Systems Approach 4th Edition by Marjorie Kelly Cowan
Edition 4ISBN: 978-0073402437
Microbiology: A Systems Approach 4th Edition by Marjorie Kelly Cowan
Edition 4ISBN: 978-0073402437 Exercise 13
From chapter 3, figure 3.5 b. What biochemical characteristic does this figure illustrate How could this characteristic be used to begin the identification of these organisms Explain your answer.
Figure 3.5 Examples of media that are both selective and differential.
(b) MacConkey agar selects against gram-positive bacteria. It also differentiates between lactose-fermenting bacteria (indicated by a pink-red reaction in the center of the colony) and lactose-negative bacteria (indicated by an off-white colony with no dye reaction).

Figure 3.5 Examples of media that are both selective and differential.
(b) MacConkey agar selects against gram-positive bacteria. It also differentiates between lactose-fermenting bacteria (indicated by a pink-red reaction in the center of the colony) and lactose-negative bacteria (indicated by an off-white colony with no dye reaction).
Explanation
The image in Figure 3.5b shows different...
Microbiology: A Systems Approach 4th Edition by Marjorie Kelly Cowan
Why don’t you like this exercise?
Other Minimum 8 character and maximum 255 character
Character 255

